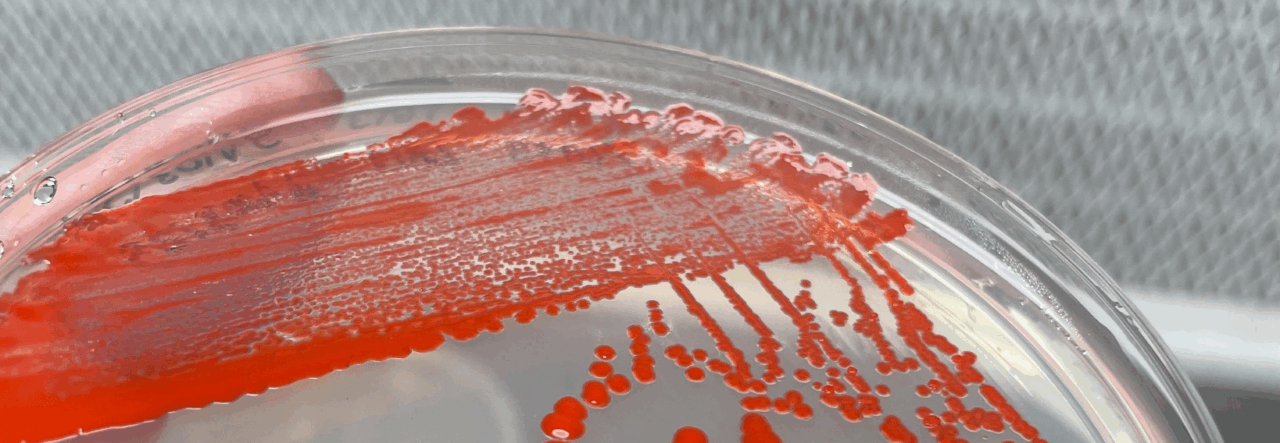

La Universidad de Los Lagos coordina el proyecto colaborativo “Desarrollo de Consorcio Bacteriano Patagónico con Potencial Biotecnológico en la Dieta de Salmones” en el marco del Fondo de Financiamiento de Proyectos de Innovación Pública con Impacto Territorial (RED 23994) con participación de las cuatro universidades estatales de la Patagonia: Universidad de Aysén, Universidad de Magallanes, Universidad de La Frontera y ULagos.
El propósito es fortalecer las capacidades científicas y tecnológicas del sur austral de Chile, bajo una perspectiva de desarrollo sustentable con enfoque One Health, para establecer un modelo de investigación aplicada que potencie el uso de microorganismos nativos con fines biotecnológicos, orientados a mejorar la sostenibilidad y eficiencia de la acuicultura nacional.
Esta iniciativa aborda no solo los desafíos productivos del sector, sino también las dimensiones ambientales y de salud animal y humana, en coherencia con los principios del enfoque One Health, que promueve la interconexión entre la salud de los ecosistemas, los animales y las personas.
En los 10 meses de duración de la iniciativa, se avanzará en la consolidación de un consorcio biotecnológico patagónico orientado a la innovación, la investigación aplicada y la transferencia de conocimiento hacia los sectores productivos.

La propuesta fue evaluada positivamente por el Comité de la Red de Innovación del CUECH, destacando su calidad técnica, pertinencia territorial y potencial de impacto regional. “Este proyecto refleja el compromiso de las universidades estatales con el desarrollo científico responsable y con una mirada país desde la Patagonia. A través de la biotecnología y el enfoque One Health, buscamos generar soluciones que aporten a la sostenibilidad de la acuicultura y a la protección de nuestros ecosistemas australes”, destacó el Dr. Alex González, director del Programa de Biomedicina y Biotecnología de la Universidad de Los Lagos y coordinador del proyecto.
Esta adjudicación representa un nuevo paso en la estrategia de la ULagos por fortalecer la cooperación interuniversitaria y posicionar la ciencia y la biotecnología como motores del desarrollo sustentable para la Patagonia chilena, en consonancia con la misión de las universidades estatales y su vocación territorial.
Publicado por: Natalia Araya Raccoursier